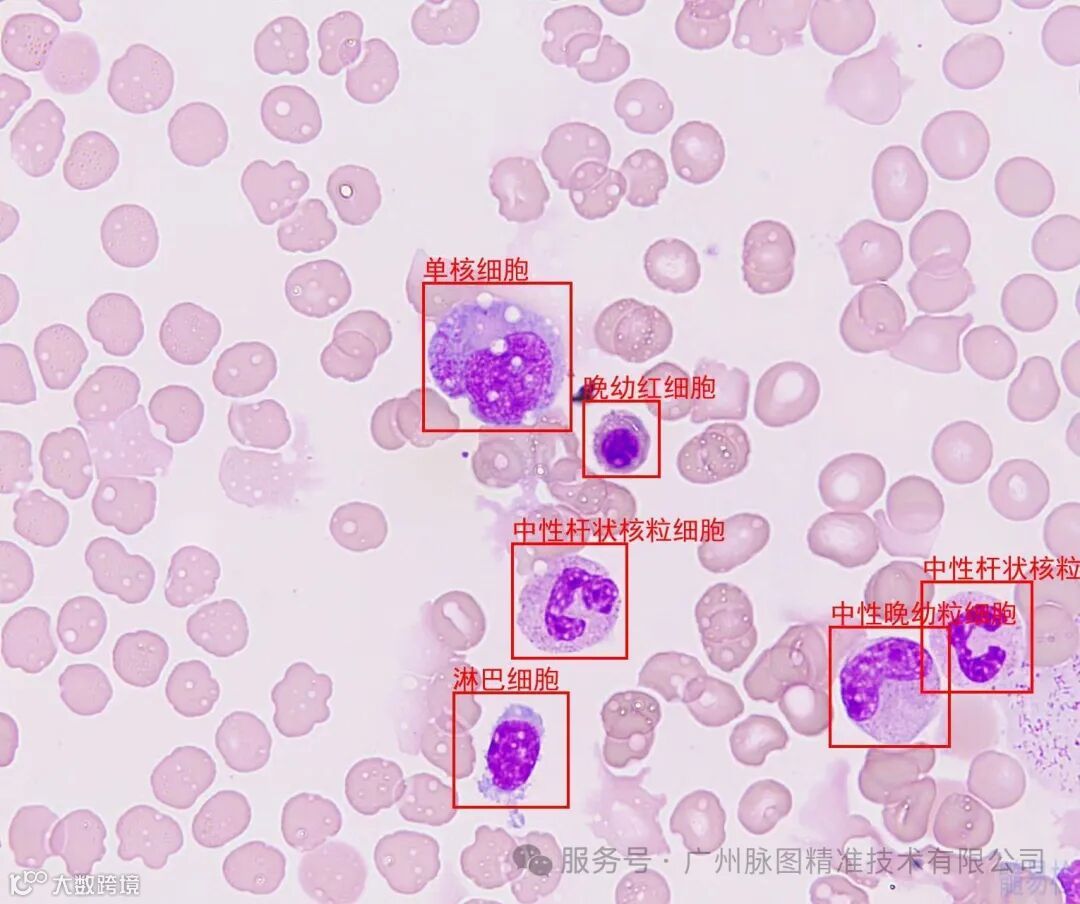

"髓易检"操作流程
核心用途
通过AI图像识别技术,快速识别细胞类型(如血细胞、病理细胞等),辅助学习、科研或医疗场景。
高准确率
支持实时拍照或上传图片
提供详细细胞特征属性解析
使用步骤
打开微信服务号,搜索“广州脉图”(广州脉图精准技术有限公司),点击关注服务号,点开左下角小程序,在右下角【我的】登录,填写信息,完成注册。

进入
1、打开小程序,首页点击【拍照上传/导入图像】按钮。

功能
1、实时拍照(对准显微镜中的细胞,保持光线均匀)。
2、从相册选择已有细胞图片导入图像(支持JPG/PNG格式)。
分析列表
1、自动生成结果,标注识别出的细胞名称。
2、分析完可点击图片长按进行保存。


图 例

注意事项:
① 图像质量:避免模糊、反光或重叠细胞,建议放大至清晰视野。
② 局限性:复杂样本(如高度混合细胞群)可能需人工复核。
③ 非诊断工具(医疗用途需专业验证)。
使用须知:
1、用户需确保上传的样本图像符合法律法规及伦理要求(如不涉及他人隐私或敏感数据),因不当使用导致的纠纷由用户自行承担。
2、我司不对识别结果进行任何解释工作。
3、细胞识别结果基于算法模型生成,可能受图像质量、拍摄条件、样本类型等因素影响,不保证100%准确性。如需临床或科研用途,请咨询专业人士并辅以实验室检测。
4、本小程序提供的细胞识别功能及相关分析结果仅用于科研参考、教育学习或兴趣探索,不可替代专业医学诊断。用户不应以本程序的识别结果作为医疗决策依据。
5、本页资料仅供参考,内容可能调整,恕不另行通知。

长按二维码关注服务号

长按二维码添加好友
更多产品资讯早知道
广州脉图精准技术有限公司
电话丨020-31041932
18924163727(微信同号)
点击二维码 关注我们

